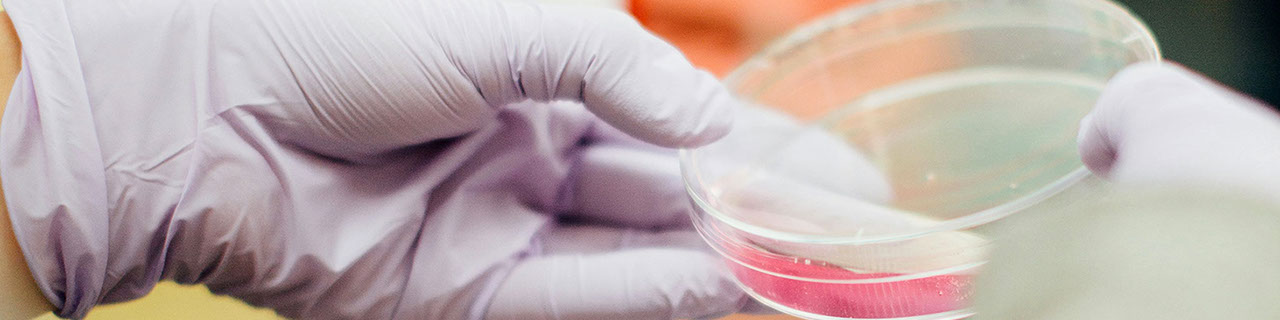

[ ENGLISH ]

DBG 2025
#GesundeBödenKlimaschutz
13. – 18. September 2025
Universität Tübingen
IMPRESSUM | DSGVO
Bitte beachten Sie folgenden ergänzenden Hinweis zum Datenschutz:
Auf unseren Veranstaltungen werden wir Sie bitten, ein Namensschild zu tragen. Des Weiteren ist es möglich, dass auf den von uns organisierten Veranstaltungen fotografiert oder gefilmt wird, dass Presse anwesend ist, dass Vorträge übertragen werden, es Videokonferenzen gibt oder Livestreamings mit und ohne Aufzeichnung. Genauere Informationen erhalten Sie dazu gern auf Anfrage und vor Ort auf der Veranstaltung.
Impressum
F&U confirm GbR
Geschäftsführung: Dr. Hildegard Feldmann und Ogarit Uhlmann MSc.
Sitz der Gesellschaft: Leipzig
Steuer-Nr.: 232 / 166 / 19501
Ust-IdNr.: DE 197341171
Haftung für Inhalte und Links: F&U confirm haftet nicht für die Richtigkeit der Inhalte, Vollständigkeit, Fehler jeglicher Art, Auslassungen sowie für die Aktualität auf diesen Webseiten. Die Nutzung dieser Webseite erfolgt auf eigene Gefahr. Trotz sorgfältiger inhaltlicher Kontrolle übernimmt F&U confirm keine Haftung für die Inhalte von Links zu externen Webseiten Dritter. Diese Webseiten und ihre Inhalte unterliegen der Haftung des jeweiligen Betreibers.
Bildnachweis: unsplash.com, pixabay.com
Webmaster: Ogarit Uhlmann, Mario Helm
Dr. Hildegard Feldmann & Ogarit Uhlmann MSc.
F&U confirm GbR
Wissenschaftliche Veranstaltungen: Organisation, Konzepte, Publikationen
Permoserstraße 15 | 04318 Leipzig | BRD | Tel. 0341 6025-5810 E-Mail conference (at) fu-confirm.de
Datenschutzerklärung, Stand vom 20. Mai 2024
Wir freuen uns über Ihr Interesse an unserer Webseite. Im Folgenden finden Sie ausführliche Informationen über Datenschutz und den Umgang mit Ihren Daten.
Mit der nachfolgenden Datenschutzerklärung kommen wir unserer gesetzlichen Informationspflicht nach und klären Nutzer*innen über Art, Umfang und Zweck der Erhebung und Verwendung personenbezogener Daten durch uns auf.
Datenschutz
Die Betreiber dieser Seiten nehmen den Schutz Ihrer persönlichen Daten sehr ernst. Wir behandeln Ihre personenbezogenen Daten vertraulich und entsprechend der gesetzlichen Datenschutzvorschriften sowie dieser Datenschutzerklärung.
Die Nutzung unserer Website ist in der Regel ohne Angabe personenbezogener Daten möglich. Soweit auf unseren Seiten personenbezogene Daten (beispielsweise Name, Anschrift oder E-Mail-Adressen) erhoben werden, erfolgt dies stets auf freiwilliger Basis. Diese Daten werden ohne Ihre ausdrückliche Zustimmung nicht an Dritte weitergegeben.
Wir weisen darauf hin, dass die Datenübertragung im Internet (z.B. bei der Kommunikation per E-Mail) Sicherheitslücken aufweisen kann. Ein lückenloser Schutz der Daten vor dem Zugriff durch Dritte ist nicht möglich.
Verantwortlichkeit
Verantwortliche Stelle im Sinne der Datenschutzgesetze, insbesondere der EU-Datenschutzgrundverordnung (EU-DSGVO), sind:
Dr. Hildegard Feldmann & Ogarit Uhlmann MSc. F&U confirm GbR
Wissenschaftliche Veranstaltungen: Organisation, Konzepte, Publikationen
Permoserstraße 15 | 04318 Leipzig | BRD
Telefon: +49 341 235 2264
E-Mail: conference@fu-confirm.de
Webseite: http://www.fu-confirm.de
Ihre Betroffenenrechte
Unter den angegebenen Kontaktdaten können Sie jederzeit folgende Rechte ausüben:
• Auskunft über Ihre bei uns gespeicherten Daten und deren Verarbeitung,
• Berichtigung unrichtiger personenbezogener Daten,
• Löschung Ihrer bei uns gespeicherten Daten,
• Einschränkung der Datenverarbeitung, sofern wir Ihre Daten aufgrund gesetzlicher Pflichten noch nicht löschen dürfen,
• Widerspruch gegen die Verarbeitung Ihrer Daten bei uns und
• Datenübertragbarkeit, sofern Sie in die Datenverarbeitung eingewilligt haben oder einen Vertrag mit uns abgeschlossen haben.
Sofern Sie uns eine Einwilligung erteilt haben, können Sie diese jederzeit mit Wirkung für die Zukunft widerrufen.
Sie können sich jederzeit mit einer Beschwerde an die für Sie zuständige Aufsichtsbehörde wenden. Ihre zuständige Aufsichtsbehörde richtet sich nach dem Bundesland Ihres Wohnsitzes, Ihrer Arbeit oder der mutmaßlichen Verletzung. Eine Liste der Aufsichtsbehörden (für den nichtöffentlichen Bereich) mit Anschrift finden Sie unter: https://www.bfdi.bund.de/DE/Infothek/Anschriften_Links/anschriften_links-node.html.
Zwecke der Datenverarbeitung durch die verantwortliche Stelle und Dritte
Wir verarbeiten Ihre personenbezogenen Daten nur zu den in dieser Datenschutzerklärung genannten Zwecken. Eine Übermittlung Ihrer persönlichen Daten an Dritte zu anderen als den genannten Zwecken findet nicht statt. Wir geben Ihre persönlichen Daten nur an Dritte weiter, wenn:
• Sie Ihre ausdrückliche Einwilligung dazu erteilt haben,
• die Verarbeitung zur Abwicklung eines Vertrags mit Ihnen erforderlich ist,
• die Verarbeitung zur Erfüllung einer rechtlichen Verpflichtung erforderlich ist,
• die Verarbeitung zur Wahrung berechtigter Interessen erforderlich ist und kein Grund zur Annahme besteht, dass Sie ein überwiegendes schutzwürdiges Interesse an der Nichtweitergabe Ihrer Daten haben.
Löschung bzw. Sperrung der Daten
Wir halten uns an die Grundsätze der Datenvermeidung und Datensparsamkeit. Wir speichern Ihre personenbezogenen Daten daher nur so lange, wie dies zur Erreichung der hier genannten Zwecke erforderlich ist oder wie es die vom Gesetzgeber vorgesehenen vielfältigen Speicherfristen vorsehen. Nach Fortfall des jeweiligen Zweckes bzw. Ablauf dieser Fristen werden die entsprechenden Daten routinemäßig und entsprechend den gesetzlichen Vorschriften gesperrt oder gelöscht.
Erfassung allgemeiner Informationen beim Besuch unserer Website
Wenn Sie auf unsere Website zugreifen, werden automatisch mittels eines Cookies Informationen allgemeiner Natur erfasst. Diese Informationen (Server-Logfiles) beinhalten
IP-Adresse,
Datum des Zugriffs,
angefordertes Dokument,
HTTP-Response-Code,
vom Browser übermittelte Systemdaten (Browser, Betriebssystem, Version).
Diese Informationen sind technisch notwendig, um von Ihnen angeforderte Inhalte von Webseiten korrekt auszuliefern und fallen bei Nutzung des Internets zwingend an. Sie werden insbesondere zu folgenden Zwecken verarbeitet:
Sicherstellung eines problemlosen Verbindungsaufbaus der Website,
Sicherstellung einer reibungslosen Nutzung unserer Website,
Auswertung der Systemsicherheit und -stabilität sowie
zu weiteren administrativen Zwecken.
Die Verarbeitung Ihrer personenbezogenen Daten basiert auf unserem berechtigten Interesse aus den vorgenannten Zwecken zur Datenerhebung. Wir verwenden Ihre Daten nicht, um Rückschlüsse auf Ihre Person zu ziehen. Empfänger der Daten sind nur die verantwortliche Stelle und ggf. Auftragsverarbeiter.
Anonyme Informationen dieser Art werden von uns ggfs. statistisch ausgewertet, um unseren Internetauftritt und die dahinterstehende Technik zu optimieren.
Anmeldung zu einer von uns organisierten Veranstaltung (z.B. Tagung, Kongress, Workshop, Seminar, Symposium u.a.m.)
Für eine Anmeldung zu einer von uns organisierten Veranstaltung werden persönliche Daten von Ihnen erhoben. Das Erheben, Speichern und weitere Verarbeiten Ihrer persönlichen Daten ist dabei unumgänglich. Dies geschieht ausschließlich zum Zweck der Vorbereitung, Organisation und Durchführung der betreffenden Veranstaltung.
Diese Daten werden nur in Abstimmung mit Ihnen an Dritte weitergegeben, die direkt in die organisatorische Vor- und Nachbereitung sowie Durchführung der Veranstaltung einbezogen sind (z.B. Programmkomitee, Hotel) und wenn die organisatorischen Abläufe dies erforderlich machen sollten.
Änderung unserer Datenschutzbestimmungen
Wir behalten uns vor, diese Datenschutzerklärung anzupassen, damit sie stets den aktuellen rechtlichen Anforderungen entspricht oder um Änderungen unserer Leistungen in der Datenschutzerklärung umzusetzen, z.B. bei der Einführung neuer Services. Für Ihren erneuten Besuch gilt dann die neue Datenschutzerklärung.
Fragen
Wenn Sie Fragen zum Datenschutz haben, schreiben Sie uns bitte eine E-Mail oder wenden Sie sich direkt an die für den Datenschutz verantwortlichen Personen in unserer Firma:
Frau Dr. Hildegard Feldmann & Frau Ogarit Uhlmann MSc.
F&U confirm
Permoserstraße 15 | 04318 Leipzig | BRD
Telefon: +49 341 6025-5810
E-Mail: conference@fu-confirm.de
Die Datenschutzerklärung wurde mit dem Datenschutzerklärungs-Generator der activeMind AG erstellt und von den Verantwortlichen modifiziert.
News
*[Durch Anklicken des Links
werden Sie zu Converia, unserer Konferenzmanagementsoftware, weitergeleitet.]
Kalendereintrag:
KONTAKT
F&U confirm
Permoserstraße 15
04318 Leipzig | BRD
Tel.: +49 (0)341 6025 1827
Bitte beachten Sie folgenden ergänzenden Hinweis zum Datenschutz:
Auf unseren Veranstaltungen werden wir Sie bitten, ein Namensschild zu tragen. Des Weiteren ist es möglich, dass auf den von uns organisierten Veranstaltungen fotografiert oder gefilmt wird, dass Presse anwesend ist, dass Vorträge digital übertragen werden, es Videokonferenzen gibt oder Livestreamings mit und ohne Aufzeichnung. Genauere Informationen erhalten Sie dazu gern auf Anfrage und vor Ort auf der Veranstaltung.